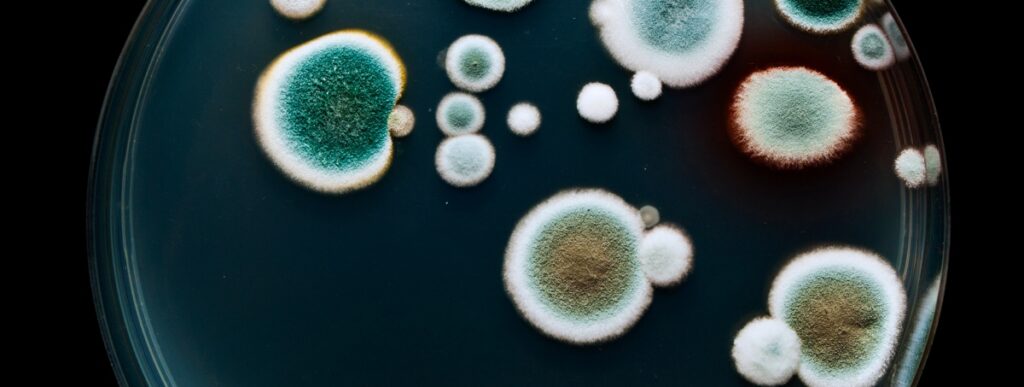

In this series of articles, NIZO Food Research Division Manager and FoodNavigator advisory panel member René Floris discusses some of the big issues in today’s food industry.
When you discover spoilage in a food product or ingredient, time is of the essence to minimise the damage – both financially and to your reputation. To prevent more product from being impacted, you have to determine the source of spoilage, but it may not be what you expect… Marjon Wells-Bennik, NIZO’s Principal Scientist Food Quality and Risk Assessment, and Karin Beekmann, NIZO Project Manager Microbiology and Food Quality, explain why you need to consider that the root cause of chemical spoilage might actually be microbial.
When we talk about ‘chemical spoilage’, we are referring to unwanted chemical reactions that can reduce food quality or stability. Light, oxygen, heat, humidity, temperature and contamination by various compounds are some of the most common culprits. However, physico-chemical spoilage can also be caused by microbial activity that can impact everything from colour, taste, smell and texture, to shelf life. When faced with a spoilage problem, manufacturers often analyse the physico-chemical properties of the raw ingredients and finished products, and assess the processes and packaging. But if the root cause of the spoilage is microbial, these analyses will not solve the issue.
Microorganisms can cause spoilage both directly and indirectly. Unwanted spoilage bacteria can grow in a food and result in, for instance, gas or undesirable putrid or acid compounds. This type of microbial spoilage is often easy to recognise. But sometimes, undesirable off-flavours are present even when spoilage of the product is not obvious.
To give one example, this is what happens with Alicyclobacillus contamination in fruit drinks containing vanillin. The bacteria convert the vanillin into guaiacol, which has a very strong off-odour.

Other bacteria produce enzymes that can deteriorate food, breaking down proteins, carbohydrates, fats and other food components. Pseudomonas, for example, are a common concern in dairy products. The bacteria are inactivated by heating, but their heat-stable enzymes remain in the product. Such enzymes can break down proteins (including the casein in milk) and fats, which can result in off-flavours and discoloration in milk and cheese, amongst other spoilage issues.
To start with, the results of microbial spoilage can mimic other types of chemical spoilage very closely. A good illustration is when certain cheeses show red discoloration, known as ‘pinking.’ This can be caused by the reaction of a colouring agent such as annatto (a natural pigment commonly used in certain cheeses) with nitrite (which is added to prevent late blowing). But pinking can also be caused when certain bacteria produce pigments that discolour the cheese. Clearly, the solution to this problem will vary greatly depending on which situation you are facing.

Red coloration of cheese can have microbial causes.
Spoilage can occur far down the food chain from the original bacterial contamination, especially when enzymes are involved. The presence of enzymes may not be a problem until they come into contact with the ‘right’ substrates. For example, a skim milk powder contaminated with bacterial enzymes may not show any sign of spoilage. However, when it is used as an ingredient by a chocolate manufacturer, lipolytic enzymes can start to break down the fat in the chocolate, degrading its texture and stability. In such a case, it very difficult for the chocolate manufacturer to trace the problem back to the original bacterial contamination of the milk on their own.
You need to understand both food production and microorganisms. Each case is different, but at NIZO for example, we start by asking a lot of questions about ingredients, processes, etc. Based on that, we can pinpoint some probable causes, including microbial ones. Then we do targeted testing, using techniques such as 16S rRNA, shotgun sequencing or genome sequencing, to identify the microorganism.
Enzymatic spoilage can occur even when there are no longer any live bacteria in the food, which makes it much harder to identify the microorganism. However, DNA extraction from products and sequencing can identify whether certain microorganisms were present that are known to produce enzymes that degrade proteins or lipids, or that lead to the production of off-flavours or unwanted colour pigment in your product.
Once you know which organism you are dealing with and how it leads to spoilage, you can use your knowledge to determine the most likely entry point. Then, you can evaluate your response. In some cases, this may involve adapting cleaning, storage, pasteurisation, etc. to ensure the bacteria cannot contaminate future products. Pseudomonas, for instance, can enter the dairy plant in multiple ways, through soil, milk, water, etc., making it very difficult to completely exclude them. Once the enzymes are produced, they are also extremely difficult to get rid of. The best solution may thus be to focus on preventing the bacteria from growing and producing enzymes, by keeping milk for as little time and at as low a temperature as possible before it is pasteurised. You can combine this with careful cleaning of siloes and lines, to eliminate any biofilms that may form, and prevent recontamination.
Absolutely, although the microorganisms that cause the spoilage are often different. Plant ingredients may contain many unknown types and levels of microbes, but in recent years we have gained much knowledge on the ones that occur in various ingredients. At the same time, the plant ingredients frequently only tolerate milder processing, which does not kill off many of the potential spoilage microbes.
Sometimes, small changes can have a big impact on microbial activity or contamination, such as when you are making a product version that is ‘more natural,’ ‘healthier’ or ‘green label.’ If you reduce salt, sugar or preservatives, your processing conditions may no longer inactivate certain microbes. Or if you replace one ingredient with another, you may be opening the door to a new microbial contaminant. It’s very important to include food microbial safety and quality early in your reformulation or development process. You don’t want to go through the time and expense of developing a good-looking, tasty product, only to discover at the end that you have a shelf-life problem, for example.